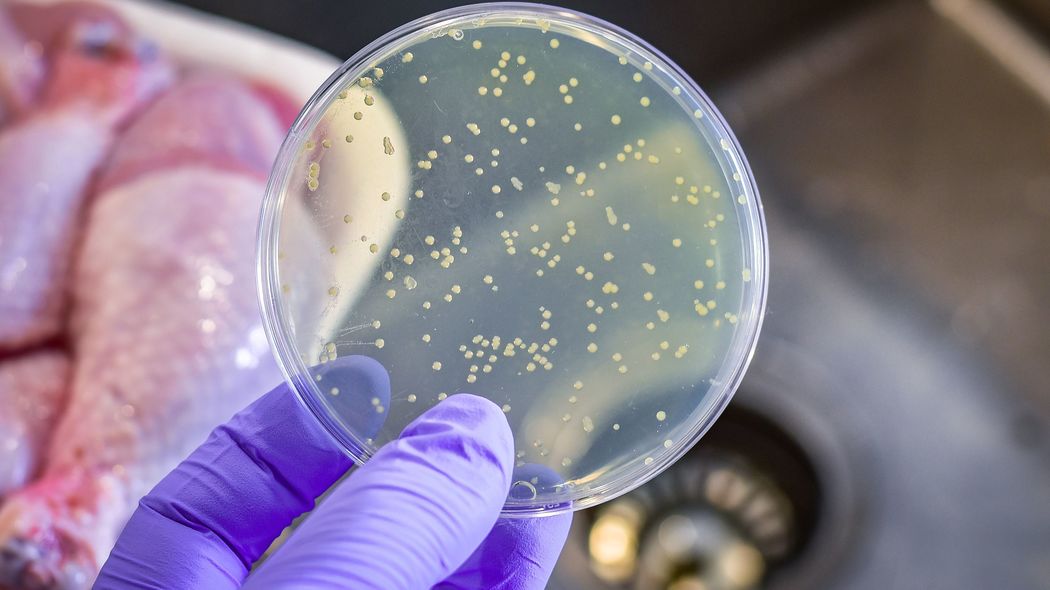
｢腐敗臭と糸引き=食中毒｣ではない…管理栄養士｢見た目と臭いではわからない食中毒の本当の怖さ｣ 夏は食中毒のハイシーズンではなかった

「食中毒」イコール「腐敗」ではない
そもそも食中毒とは、どういうものでしょうか。改めて聞かれると、うまく答えられない方もいるかもしれません。食中毒とは、飲食物などに含まれている微生物やウイルス、化学物質や自然毒が原因で起こる急性の健康被害をいいます。嘔吐や腹痛、下痢などの消化管症状や発熱が主症状ですが、命に関わる危険な状態に陥ることもあり注意が必要です。
食中毒というと、一般的に「食べ物の中で細菌などの微生物が繁殖し、腐った状態のものを食べて起こるもの」というイメージを持たれがち。だから食品の見た目や臭いをチェックすれば安心と考える人があとを絶ちません。でも腐敗臭や糸引きなどがあって、いわゆる「腐っている」とされる状態を引き起こす細菌の多くは、意外にも食中毒の原因にならないのです。
もちろん、細菌が繁殖したものを大量に食べた場合、例外的に腹痛や嘔吐が起こることもあります。また、腐敗したものを食べた後、心因性の吐き気をもよおすこともあるでしょう。学校給食の異物混入や牛乳の異臭事故で、具合の悪くなる児童・生徒が続出するのは、こうしたメカニズムによるものと推察されます。
腐敗は見た目や臭いでわかりますが、食中毒細菌が繁殖していても見た目や臭いに変化のない場合がほとんどなので、見分けることはできないことを知っておきましょう。
夏の食中毒が昔に比べ激減した理由
食中毒というと、気温や湿度の高くなる夏に多いイメージがありますね。しかし、令和3〜5年の食中毒に関する統計を調べてみると、食中毒件数は3月と10月にもっとも多く、食中毒患者数は4月と6月に多いというデータがありました。
つまり、夏に食中毒が多いというのは、もはや過去のこと。そのもっとも大きな理由は、食品の低温流通網(コールドチェーン)が構築されたためです。食品の生産、そして小売店や飲食店へ運ばれるまで輸送や保管などにおいて厳密な温度管理ができるようになったので、夏でも他の季節と同じように鮮度を保ったまま食品が届けられるようになりました。だから、食中毒のリスクが減ったのです。
その恩恵が特に大きかったのが、魚介類。昔、夏場の代表的な食中毒といえば、魚介類による「腸炎ビブリオ」でした。腸炎ビブリオは高温の海水中で活動する細菌で、夏場に水揚げされた海産物に付着していることが多く、魚介類を生で食べる習慣のある日本に多かったのです。しかし、2001年に食品衛生法が一部改正され「腸炎ビブリオ食中毒防止対策のための水産食品に係る規格及び基準」が設定され、販売する魚は真水で洗う、10度以下で保存するというルールが徹底されたことにより激減しました。